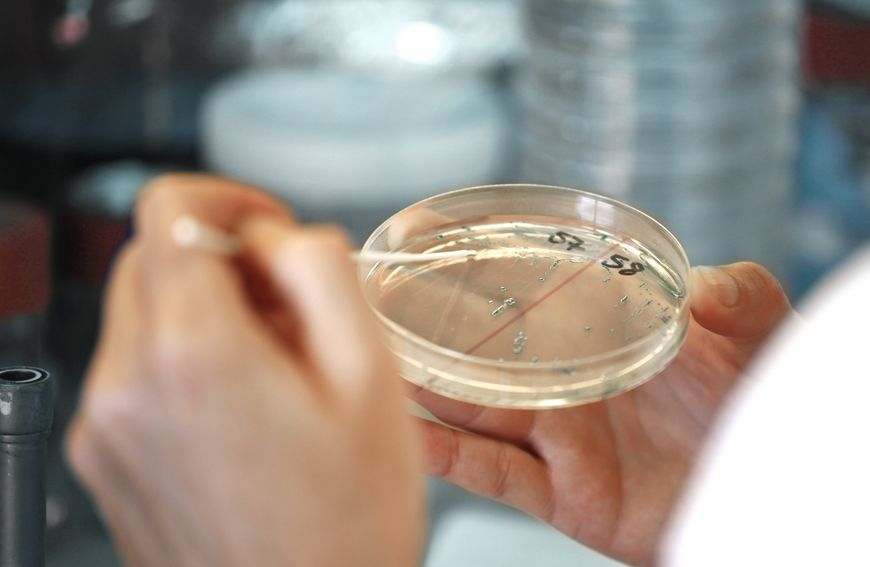
Bakteria czy wirus, to kluczowe pytanie

0
0
Brak produktów
0,00 zł
Razem:
Produkt dodany poprawnie do Twojego koszyka
Ilość:
Razem:
Ilość produktów w Twoim koszyku: 0.
Jest 1 produkt w Twoim koszyku.
Razem produkty:
Dostawa:
Do ustalenia
Razem
Publikacje